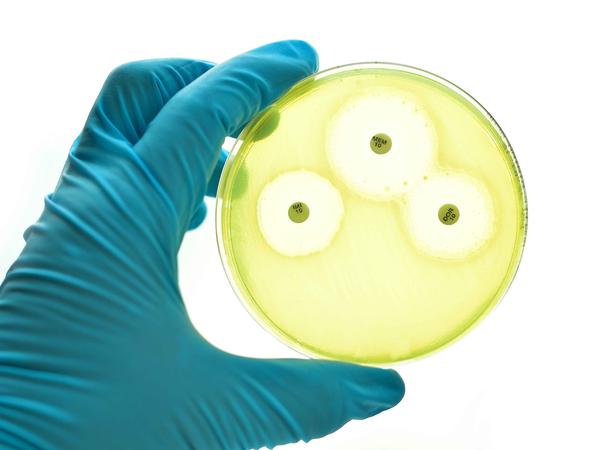

快速问医生|癌症会误诊吗?医生:会,而且误诊率不低,3点建议少走弯路

文章图片

文章图片

文章图片
文章图片
在医院进行检查时由于各种原因 , 可能会出现误诊的情况 , 而且不仅会出现在小病上 , 癌症等大病也有误诊的几率 。
相关杂志统计 , 全世界疾病的误诊率高达30%!
误诊的原因也是多种多样的 , 比如医生不够专业、患者掩盖病情、病情过于复杂等 。
以美国为例 , 这个国家的诊断设备可以被认为是世界上最好的 , 但是仍有许多误诊病例 , 据权威机构调查统计 , 美国医生的临床诊断错误率在15-45%之间 。
【快速问医生|癌症会误诊吗?医生:会,而且误诊率不低,3点建议少走弯路】在2000年 , 中国的专家分析研究40万份病历后发现 , 我国疾病的误诊率为27% , 其中癌症的误诊率已经达到40% 。
为什么癌症的误诊率比较高?
1、医疗技术水平低
如果医生的专业水平不够 , 很容易造成误诊 , 有些疾病在特定的领域比较常见 , 而当出现在其他领域时 , 医生会因为缺乏经验而做出错误的诊断 。
此外 , 医疗技术在准确性方面也存在局限性 , 许多传染病和癌症都是通过检测来诊断的 。
如果检测机器的灵敏度和准确度存在误差 , 也很可能会出现误诊 。
2、疾病症状不明显 , 掩盖性强
许多癌症在早期没有明显的症状 , 有些很容易被误认为是其他疾病 , 比如淋巴瘤 。 因为淋巴瘤的症状并不是很明显、典型 , 所以医生很容易将其当做感冒或其他疾病一样对待 。
3、医患关系差
现在很多患者对医生和医院的信任度极低 , 认为医生为了得到更多的佣金 , 会哄骗他们做一些不必要的检查 。
还有一些患者会因为不信任而掩盖自己过去的疾病史 , 使医生无法做出正确的诊断 , 因此出现误诊的情况 。
癌症患者应该如何避免误诊?
1、选择技术更好的医院和医生
相对于省级医疗资源 , 市级医院和医师有一定的滞后性 , 如果在小医院确诊癌症后 , 建议患者最好去大医院再进行一次检查 。
因为这些医院拥有更先进的医疗设备以及医疗体系 , 并且专业医生在诊断和治疗癌症方面也更有经验 。
2、充分的诊断依据
对医生而言 , 不建议单凭根据影像学检查或临床诊断对患者做出判断 , 而是提供足够的诊断证据 。
如果不确定自己的诊断 , 可以进行会诊 , 避免因不正确的诊断耽误患者的病情 。
通常情况下 , 癌症的诊断需要经历临床诊断和影像学诊断等许多步骤 , 其中最主要的就是组织病理学诊断 , 这个诊断方法更加准确 。
3、多次确认
如果前几次的检查的结果不同或不确定 , 那么建议患者可以多做几次检查 , 或者前往多家医院检查 。
如果条件有限 , 尽量寻找权威专家 , 他们的经验更丰富 , 能够有效降低误诊率 。
事实上 , 许多癌症在引起身体不适的时候 , 可能已经发展到了中期或晚期 , 如果这个时候再出现误诊 , 那么对于之后的治疗和预后影响是非常大的 。
因此 , 无论是医院、医生还是患者本身 , 都必须以认真负责的态度明确疾病的具体情况 。
经验总结扩展阅读
- 母猫人会出现难产,猫也会,当你的猫遇上难产的问题时保大还是保小呢
- 海报海报|快速有序 红桥速度
- 方法8个小诀窍 快速去掉黑眼圈
- 寒冷清晨超温馨的早上好问候短信问候大家早上好的漂亮祝福图片
- 8张最新群发冬日早上好问候动态腊月暖心早上好图片表情祝福语录
- 寒冷清晨早上好问候语阳光句子 早上好祝福图片表情
- 冬天早上好最棒的问候表情祝福语录,冬天早上好图片大全带字
- 2022最新早安图片带字不用打字聊天的冬天早上好问候祝福图片精选
- 1月20日腊月十八大寒群发清晨早上好问候祝福动态表情图片
- 寒冬腊月最新早上好表情图片大全,温馨早安问候祝福短信
